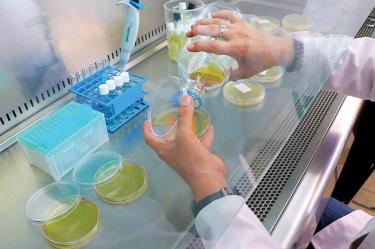
thumb

Fibra dura y cutícula de nopal como fármaco; patenta UG fibras del nopal
Se han generado esos productos a través de la descomposición orgánica de la planta
CELAYA, Gto.
Investigadores de la Universidad de Guanajuato (UG) patentaron procesos y resultados científicos para la obtención de la cutícula del nopal y su fibra dura, los cuales son utilizados en biotecnología agroindustrial y la agroindustria farmacéutica.
Estudiantes y académicos del Campus Celaya-Salvatierra de la UG han generado estos productos para la industria a través de la descomposición orgánica del nopal; lo cual derivó en la obtención de una patente.
De acuerdo con Lorena Vargas Rodríguez, titular del Departamento de Ingeniería Agroindustrial de la División de Ciencias de la Salud e Ingenierías del Campus Celaya-Salvatierra, a través de este trabajo de investigación se logró el reconocimiento de la patente por el Instituto Mexicano de la Propiedad Intelectual ‘Proceso de Obtención de Fibra Dura y Cutícula de Nopal’.
La patente universitaria consiste, según la misma UG, en proteger el proceso en el que se obtienen estos dos productos, además se caracteriza al ser un proceso de descomposición de la materia orgánica del nopal asistido con nejayote, es decir, el agua residual.
Es conocida la importancia del tratamiento adecuado de residuos a nivel mundial, por lo que contar con una investigación que permite el aprovechamiento adecuado de éstos incrementa la importancia de esta investigación por el uso consciente de los residuos, como el nejayote, el cual a su vez es rico en materia orgánica.
Esta patente es diferente a otras porque en ésta se protege el proceso con la obtención de dos productos valiosos como la cutícula y la fibra dura o fibra vascular del nopal, materiales muy promisorios para la industria alimentaria y no alimentaria.
Actualmente estos procesos están en investigación, pues se busca lograr otra patente, pero para la aplicación de la cutícula del nopal, la cual es gruesa y cerosa y evita la evapotranspiración.
Es importante mencionar que desde el 2021 la Licenciatura en Ingeniería Agroindustrial del CCS se modernizó para promover la formación de investigadores que aporten valor al conjunto de procesos de producción, industrialización, distribución y consumo de productos agropecuarios, forestales y otros recursos naturales, en diferentes escalas, que impacten en el bienestar de las personas.
Este rediseño incluye la investigación, la biotecnología agroindustrial y la agroindustria farmacéutica, que permite la ampliación en el campo de acción de los profesionistas egresados de este programa educativo.
EL EDITOR RECOMIENDA
Semar busca veleros que navegaban con ayuda humanitaria a Cuba
Nacional 2 min de lectura
Bajo asedio legal, se despiden tres consejeros del INE
Nacional 4 min de lectura